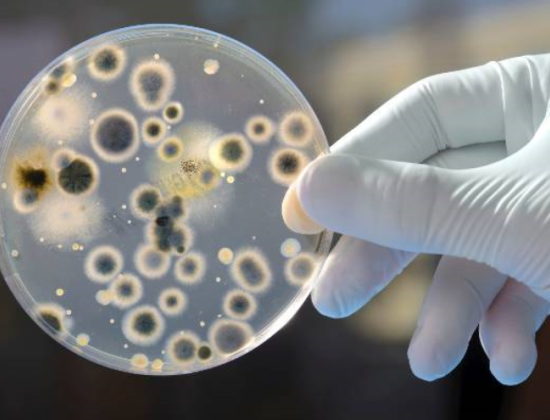

Čistoća i besprijekoran mineralni sastav zaokružuju svilenkast okus svake kapi vode Jana, a sve to zahvaljujući jedinstvenoj dubini izvora na čak 800 m dubine.
Iako u rujnu još uvijek uživamo u toplim kasnoljetnim danima, stručnjaci kažu da je upravo sada vrijeme da pojačamo unos vitamina i minerala te ojačamo imunitet i pripremimo ga na jesenske izazove.
Stoljećima su pčele bile jedina stvorenja koja su znala kako iz biljke izvući slatki nektar i koncentrirati ga u polu tekući oblik šećera, odnosno u med. Prije samo dvije stotine godina kristalizirana pločica šećera je bila veoma skupa i rijetka poslastica.
Prema pisanju časopisa Proceedings of the National Academy of Sciences (PNAS) objavljeno je zajedničko istraživanje znanstvenika s britanskog Sveučilišta East Anglija i američkog nacionalng laboratorija Pacific Northwest iz Wa